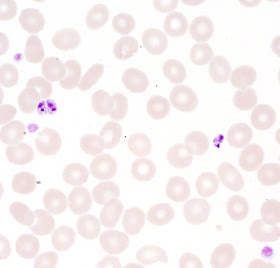

Answer: Rhinosporidiosis (infection with
Rhinosporidium seeberi)
Congratulations to Anonymous (x 3!), Kenneth, Chris, Victor, and Santoshpath who all got this correct! The keys to the diagnosis is the clinical history (location in nasal mucosa), exposure history (India), and histopathologic features of a polypoid mass containing mature sporangia (large, thick-walled spherical structures) and smaller internal sporangiospores (daughter cells). The sporangia stain with the fungal stains Gomori methenamine silver (GMS) and periodic acid-Schiff (PAS), and may mimic the appearance of similar appearing fungi such as
Coccidiodes immitis (as one viewer suggested) and
Chrysosporium spp. (the agent of adiaspiromycosis). Myospherulosis, a non-infectious entity, is also in the differential diagnosis. The difference between these entities is in the size of the spherule/sporangia and the internal structures.
This organism was previously considered to be a fungus, but it is now considered to be an aquatic protistan parasite (classified under Mesomycetozoea, which includes parasites of fish and amphibians). Rhinosporidiosis is endemic in India, Sri Lanka, South America, and Africa.
Although the disease most commonly involves the mucosa of the nose, mouth, and conjunctiva, involvement of the skin, ear, genitals, and rectum has also been described. Disseminated infection has been described in 3 individuals.
Thank you all for viewing and writing in!






.jpg)
.jpg)
.jpg)